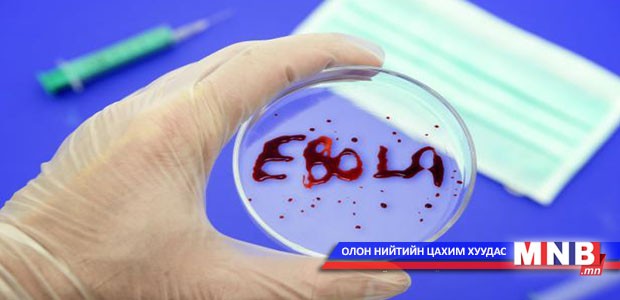

Эбола вирусын халдвараар 5000 гаруй хүн амь үрэгдэж, 13 мянга гаруй хүн өвчлөөд буй. Энэхүү халдвар анх баруун Африкийн Гвиней улсад гарч хөрш Либери, Сьерра-Леоне, Сенегал, Нигери, Конго, Мали улсад тархсан. Харин үүнээс Сенегал, Нигери, Конго улс Эбола вирусын халдвараас бүрэн ангижраад байгаа аж. Мөн Либери улс өнгөрсөн ням гарагт онц байдлаа цуцласан байна. Либерийн Ерөнхийлөгч сарын дараа болох Зул сарын баяраас өмнө Эбола вирусын халдвараас ангижрах найдлага тавьж буй аж. Эбола вирусын халдвар сүүлийн 42 хоногт шинээр бүртгэгдээгүй бол өвчнөөс ангижирсан гэж үздэг аж. Эбола вирусын халдварын нууц үе 21 хоног байдаг гэнэ.
| Сенегал, Нигери, Конго улс эбола вирусээс ангижирчээ | ||
| Үзсэн: 1556 | Mongolian National Broadcaster |


 Үндэсний телевиз
Үндэсний телевиз














































































































 Лханаагийн Мөнхтөр
Лханаагийн Мөнхтөр

 Р.Слава
Р.Слава

 Б.Цоожчулуунцэцэг
Б.Цоожчулуунцэцэг





Сэтгэгдэл бичих:
АНХААРУУЛГА: Уншигчдын бичсэн сэтгэгдэлд MNB.mn хариуцлага хүлээхгүй болно. ТА сэтгэгдэл бичихдээ хууль зүйн болон ёс суртахууны хэм хэмжээг хүндэтгэнэ үү. Хэм хэмжээг зөрчсөн сэтгэгдэлийг админ устгах эрхтэй. Сэтгэгдэлтэй холбоотой санал гомдолыг 70127055 утсаар хүлээн авна.